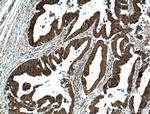
VPS33B Antibody in Immunohistochemistry (Paraffin) (IHC (P))

Search
Proteintech
VPS33B Polyclonal Antibody
{{$productOrderCtrl.translations['antibody.pdp.commerceCard.promotion.promotions']}}
{{$productOrderCtrl.translations['antibody.pdp.commerceCard.promotion.viewpromo']}}
{{$productOrderCtrl.translations['antibody.pdp.commerceCard.promotion.promocode']}}: {{promo.promoCode}} {{promo.promoTitle}} {{promo.promoDescription}}. {{$productOrderCtrl.translations['antibody.pdp.commerceCard.promotion.learnmore']}}
产品信息
12195-1-AP
种属反应
已发表种属
宿主/亚型
分类
类型
抗原
偶联物
形式
浓度
规格
纯化类型
保存液
内含物
保存条件
运输条件
产品详细信息
Immunogen sequence: MDIKQMKNF VSQELKGLKQ EHRLLSLHIG ACESIMKKKT KQDFQELIKT EHALLEGFNI RESTSYIEEH IDRQVSPIES LRLMCLLSIT ENGLIPKDYR SLKTQYLQSY GPEHLLTFSN LRRAGLLTEQ APGDTLTAVE SKVSKLVTDK AAGKITDAFS SLAKRSNFRA ISKKLNLIPR VDGEYDLKVP RDMAYVFSGA YVPLSCRIIE QVLERRSWQG LDEVVRLLNC SDFAFTDMTK EDKASSESLR LILVVFLGGC TFSEISALRF LGREKGYRFI FLTTAVTNSA RLMEAMSEVK A (318-617 aa encoded by BC016445)
靶标信息
Vesicle mediated protein sorting plays an important role in segregation of intracellular molecules into distinct organelles. Genetic studies in yeast have identified more than 40 vacuolar protein sorting (VPS) genes involved in vesicle transport to vacuoles. This gene is a member of the Sec-1 domain family, and encodes the human ortholog of rat Vps33b which is homologous to the yeast class C Vps33 protein. The mammalian class C Vps proteins are predominantly associated with late endosomes/lysosomes, and like their yeast counterparts, may mediate vesicle trafficking steps in the endosome/lysosome pathway.
仅用于科研。不用于诊断过程。未经明确授权不得转售。
生物信息学
蛋白别名: FLJ14848; hVPS33B; r-vps33b; unnamed protein product; vacuolar protein sorting 33 homolog B; vacuolar protein sorting 33 homolog B (yeast) isoform VPS33B_1; vacuolar protein sorting 33 homolog B (yeast) isoform VPS33B_2; vacuolar protein sorting 33 homolog B (yeast) isoform VPS33B_3; vacuolar protein sorting 33-like protein B; vacuolar protein sorting 33B; vacuolar protein sorting homolog r-vps33b; Vacuolar protein sorting-associated protein 33B; VPS33B
基因别名: KDIDAR; PFIC12; VPS33B
UniProt ID: (Human) Q9H267, (Mouse) P59016, (Rat) Q63616
Entrez Gene ID: (Human) 26276, (Mouse) 233405, (Rat) 64060